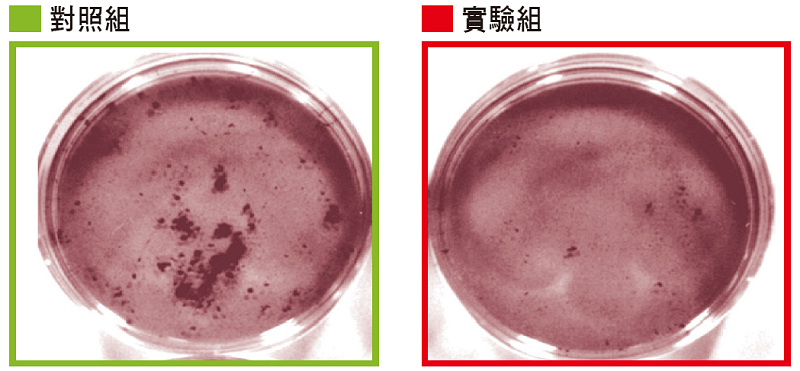

文/蘇立仁博士(國立中央大學生醫科學與工程學系副教授)
人體細胞若發生不正常增生現象,通稱為腫瘤;如果增生的細胞不會侵犯身體其他部位,醫學上稱之為良性腫瘤或囊腫;但如果細胞分裂增生的機制失控,甚至會局部地侵入正常組織,或透過體內的循環系統和淋巴系統到達遠端器官,那就是惡性腫瘤,簡稱癌症。
世界各國,尤其是先進國家,癌症都是非常重大且盛行率極高的疾病;在台灣,更是蟬聯30年以上的國人十大死因冠軍。1971年,美國總統尼克森曾提出「要向癌症宣戰」,到了50年後的今天,雖然醫學的發展漸趨成熟,但仍無法終結癌症,而且每年的罹癌人數與死亡人數還逐年升高。
目前已知人體內的癌症種類超過100種,而造成癌症的因素也非常多,基本上可分為先天性與後天性的因素。
先天性因素主要是遺傳,藉由父母的基因遺傳,而得到導致癌症的基因或缺損基因,例如先天BRCA1或BRCA2基因壞損。
什麼是BRCA1與BRCA2基因功能?簡單來說,就是當偵測到DNA(去氧核醣核酸)受到破壞時,這兩個基因可參與DNA的修復。然而,當這兩個基因產生缺陷時,DNA的破壞可能就無法完整修補,最終造成的結果,便是在婦女身上很容易產生乳癌或卵巢癌。
至於後天性的因素,是受生活習慣或環境影響而造成的基因表現錯亂或突變。過去數十年流行病學的研究結果發現,有幾項生活習慣與癌症有關,如抽煙、肥胖、飲食不均衡、運動不足、酗酒、暴露於紫外線或感染輻射線、暴露在重金屬汙染與空氣汙染的環境等等。
在台灣,肺腺癌是女性罹患機率與死亡率都很高的癌症,癌組織藉由生物晶片分析後發現,其中有一個名為EGFR(上皮生長因子接受體)的基因發生後天性突變,而這個發現也成為肺腺癌研究的一個重要課題。
癌細胞的特性
惡性腫瘤細胞有幾個不同於正常細胞的特性,例如不會受到細胞凋亡機制的調控、自我產生所需要的生長因子來進行細胞增生、不接受細胞之間接觸互相抑制生長的效果、本身具有侵入周邊組織或細胞的能力與促進血管新生的能力等。在這麼多不同於正常細胞的特徵中,其中涉及兩個重要的生物特性,一個是細胞週期的轉變,另一個是重新獲得細胞分化的能力。
所謂細胞週期,概括來說,可分為4期,包括DNA合成前期(G1)、DNA合成期(S)、DNA合成後期(G2)與細胞分裂期(M),這4個階段構成了整個細胞週期。
一般正常的細胞除了需要產生生殖細胞、修補組織的黏膜細胞,及受傷時要修復傷口的細胞外,絕大部分的細胞都不會進行分裂,也就是停在DNA合成前期(G1),或是DNA合成靜止期(G0)。然而癌細胞卻可以打開細胞週期,並頻繁運作,於是便增生大量的癌細胞。所以,如何抑制癌細胞進入細胞週期,與減慢細胞分裂速率,一直都是臨床醫學尋求解決的方法。
「腫瘤細胞分化程度」在臨床病理上是一個重要的鑑別指標,一般而言,除了骨髓幹細胞與生殖細胞外,大多數的正常細胞都是已分化完全的細胞,比較不會改變自己現有的特性狀態,然而癌細胞卻具有分化不完全的特性,於是當外在環境不利於它的生長時,就會改變自身特性來應付不良的環境。
血管新生作用就是典型的例子,當環境所需的營養不夠使用時,癌細胞就會轉型改變自身現有的特性,去分泌血管的新生因子,讓遠處周邊的血管延伸到腫瘤部位,以提供癌細胞更多養分。
另外像癌轉移和抗藥特性也是如此;在病理學的觀念裡,腫瘤分化等級愈差,癌症的惡性程度愈嚴重,這意味癌症患者存活下來或癒後復原的機率是相對低的。
禪定扮演整合治療重要角色
禪定在癌症醫療的應用上類似中醫,幾乎都歸類於互補整合醫學(complementary medicine)或另類醫學(alternative medicine)的範疇,一般人會將禪定當作減緩放射線療法、化學療法、外科手術等過程產生不適應症或併發症時的支持治療,或是幫助因罹癌之後造成負面心理,導致憂鬱症或相關「癌症性格」的減緩方法。
過去很多相關研究也會提到,禪定有助於提升罹癌病人各方面的生活品質,生理學觀點也不只一次說明,禪定有助穩定呼吸頻率、放慢心跳頻率、安定大腦思緒,甚至還可以穩定自律神經系統。不僅如此,受大腦控制的全身發炎反應也會明顯下降,這是讓人類遠離癌症的重要關鍵。以上這些發現都指出,禪定是非常好的預防與輔助方法。
加持力可抑制癌細胞增生
不過,國立交通大學余艇教授的研究團隊,所做的一個關於禪定加持力的實驗,卻打破了「禪定僅是治療癌症的輔助角色」這個既有觀念,並於2003年發表在國外生物醫學期刊The American Journal of Chinese Medicine(1)。
他們將前列腺癌的癌細胞分為實驗組與對照組,實驗組做體外的培養,並請悟覺妙天禪師進行超生命力加持,而對照組則完全不做任何處理。

(左圖)實驗組的前列腺癌細胞經由悟覺妙天禪師以超生命力加持後,相較於未加持的對照組在癌細胞培養4天後的生長曲線趨勢,可看出明顯降低了30%。
(右圖)前列腺癌細胞經由超生命力加持的實驗組,相較於未加持的對照組,發現分化程度提升了3倍;這代表癌細胞惡化程度或可能轉移的能力明顯下降。
加持過的癌細胞經過4天的培養之後,可以看出癌細胞分裂的速率明顯減少,比原來沒有加持的細胞生長速度減緩30%(如上方左圖);但整個實驗過程中,並沒有看到癌細胞在培養過程中,發生壞死或凋亡的現象。
由此可以推測,經由加持過的癌細胞減慢了細胞週期的時間;換句話說,就是癌細胞的分裂速度變慢了,於是生長速度就不如對照組的速度。
除此之外,實驗中也檢測了前列腺癌細胞的分化程度,從上方右圖可知,分化程度愈高,代表癌細胞的惡性狀況愈低。換句話說,對於治療所產生的抗藥性能力會下降,癌細胞爬行與轉移到其他器官的能力也會大幅減少。另外,實驗中也發現,禪師以超生命力加持的實驗組,其分化的程度高過原來3倍。
最後一個是前列腺癌細胞癌化的分析實驗。由於正常細胞必須貼覆或依附在固定的表面上才能生長,但癌細胞傾向不受這個特性的影響,而可以在半固體凝膠中懸浮生長。所以這個實驗是從實驗組與對照組的培養皿中的黑色區域,來判定染色後的癌細胞生長形成聚落的情況。
從上圖可知,實驗組(右方培養皿)的細胞聚落數量遠少於對照組(左方培養皿),這表示加持過的癌細胞並無法在懸浮狀態下繼續分裂與生長,癌細胞有被減低癌化的現象。
這篇科學研究成果是一個非常重大的發現,從余艇教授的團隊研究實驗中證明,經由禪定得到超生命力加持的功效,可以產生減慢細胞週期與細胞分裂、及提高腫瘤分化的效果,不再是一般人既有觀念中,禪定只是用來穩定患者情緒、緩解治療過程所產生的後遺症與副作用,或生前最後安寧的生活品質方面的輔助醫療而已。
更重要的是,禪定可以改變與逆轉癌細胞的生理特性,轉變成比較良性的腫瘤,或像正常細胞的發展,這將啟發現代醫學研究在未來有更多方向,有助於了解如何讓癌細胞恢復為正常細胞。
參考資料:
Yu T, Tsai HL, Hwang ML. Suppressing tumor progression of in vitro prostate cancer cells by emitted psychosomatic power through Zen meditation. Am J Chin Med. 2003; 31(3): 499-507. PMID: 12943181
蘇立仁博士小檔案
● 現任:
國立中央大學生醫科學與工程學系副教授
國立中央大學科技反毒教育與研究中心主任
國立中央大學高通量實驗分析核心設施主任
財團法人博愛文化基金會董事
財團法人世界領袖教育基金會董事
中華民國天然藥物協會永久會員
愛群生醫國際董事
社團法人婦幼健康促進協會專業諮詢委員召集人